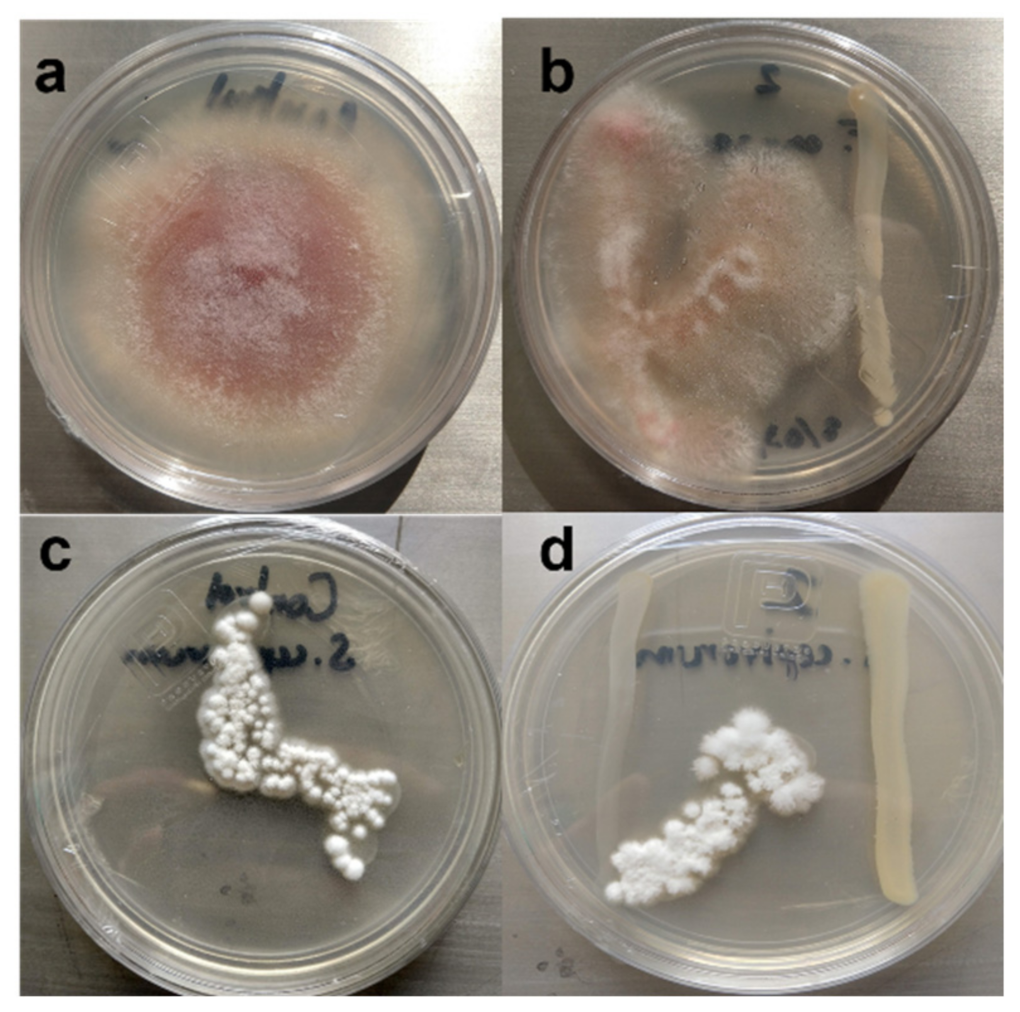
Agriculture 12 00003 g002

Isolation and Characterization of Plant Growth-Promoting Compost Bacteria That Improved Physiological Characteristics in Tomato and Lettuce Seedlings
Abstract
:1. Introduction
2. Materials and Methods
2.1. Isolation and Identification of PGPB from Mature Compost
2.1.1. Isolation of Bacteria
2.1.2. Molecular Characterization
2.1.3. Phosphate Solubilization
2.1.4. Antifungal Activity against Fusarium oxysporum and Sclerotium cepivorum
2.2. Evaluating the Effect of Bacillus Pumilus on Plant Growth
2.2.1. Preparation of Inoculum and Seed Selection
2.2.2. Effect of Bacillus pumilus on the Germination of Lettuce and Tomato Seeds
2.2.3. Effect of Bacillus pumilus on Tomato and Lettuce Seedlings
2.3. Statistical Analysis
3. Results
3.1. Isolation and Identification of PGPB from Mature Compost
3.1.1. Isolation of Bacteria Strain
3.1.2. Molecular Characterization of Isolated Bacteria and Sequence Analysis
3.1.3. Phosphate Solubilizing Activity
3.1.4. Antifungal In Vitro Activity
3.2. Bacillus pumilus Improves Plant Growth
3.2.1. Effect of Bacillus pumilus Inoculation on Seed Germination
3.2.2. Effect of Bacillus pumilus on Morphological Variables in Tomato and Lettuce Seed-Lings
4. Discussion
5. Conclusions
Author Contributions
Funding
Institutional Review Board Statement
Informed Consent Statement
Data Availability Statement
Acknowledgments
Conflicts of Interest
References
- Ferreira, C.M.H.; Soares, H.M.M.; Soares, E.V. Science of the Total Environment Promising bacterial genera for agricultural practices: An insight on plant growth-promoting properties and microbial safety aspects. Sci. Total Environ. 2019, 682, 779–799. [Google Scholar] [CrossRef] [Green Version]
- Creus, C.M. Inoculantes microbianos: Piezas de un rompecabezas que aún requiere ser ensamblado. Rev. Argent. Microbiol. 2017, 49, 207–209. [Google Scholar] [CrossRef]
- Ramakrishna, W.; Yadav, R.; Li, K. Plant growth promoting bacteria in agriculture: Two sides of a coin. Appl. Soil Ecol. 2019, 138, 10–18. [Google Scholar] [CrossRef]
- Bargaz, A.; Elhaissoufi, W.; Khourchi, S.; Benmrid, B.; Borden, K.A.; Rchiad, Z. Benefits of phosphate solubilizing bacteria on belowground crop performance for improved crop acquisition of phosphorus. Microbiol. Res. 2021, 252, 126842. [Google Scholar] [CrossRef] [PubMed]
- Stutter, M.I.; Shand, C.A.; George, T.S.; Blackwell, M.S.A.; Bol, R.; MacKay, R.L. Recovering phosphorus from soil: A root solution? Environ. Sci. Technol. 2012, 46, 1977–1978. [Google Scholar] [CrossRef] [PubMed]
- Nash, D.M.; Haygarth, P.M.; Turner, B.L.; Condron, L.M.; McDowell, R.W.; Richardson, A.E. Using organic phosphorus to sustain pasture productivity: A perspective. Geoderma 2014, 221, 11–19. [Google Scholar] [CrossRef]
- Alavi, N.; Daneshpajou, M.; Shirmardi, M.; Goudarzi, G.; Neisi, A.; Babaei, A.A. Investigating the efficiency of co-composting and vermicomposting of vinasse with the mixture of cow manure wastes, bagasse, and natural zeolite. Waste Manag. 2017, 69, 117–126. [Google Scholar] [CrossRef]
- Milinković, M.; Lalević, B.; Jovičić-Petrović, J.; Golubović-Ćurguz, V.; Kljujev, I.; Raičević, V. Biopotential of compost and compost products derived from horticultural waste—Effect on plant growth and plant pathogens’ suppression. Process Saf. Environ. Prot. 2019, 121, 299–306. [Google Scholar] [CrossRef]
- Suárez-Estrella, F.; Jurado, M.M.; López, M.J.; López-González, J.A.; Moreno, J. Role of bacteria isolated from a plant waste-based compost producing bioactive substances in the control of bacterial spot syndrome caused by Xanthomonas campestris pv. vesicatoria. Biocatal. Agric. Biotechnol. 2019, 20, 101198. [Google Scholar] [CrossRef]
- Timmusk, S.; Behers, L.; Muthoni, J.; Muraya, A.; Aronsson, A.C. Perspectives and Challenges of Microbial Application for Crop Improvement. Front. Plant Sci. 2017, 8, 49. [Google Scholar] [CrossRef] [Green Version]
- Hernández-Soberano, C.; Ruíz-Herrera, L.F.; Valencia-Cantero, E. Endophytic bacteria Arthrobacteragilis UMCV2 and Bacillus methylotrophicus M4-96 stimulate achene germination, in vitro growth, and greenhouse yield of strawberry (Fragaria × ananassa). Sci. Hortic. 2020, 261, 109005. [Google Scholar] [CrossRef]
- Huang, P.; de-Bashan, L.; Crocker, T.; Kloepper, J.W.; Bashan, Y. Evidence that fresh weight measurement is imprecise for reporting the effect of plant growth-promoting (rhizo) bacteria on growth promotion of crop plants. Biol. Fertil. Soils 2017, 53, 199–208. [Google Scholar] [CrossRef]
- Kuri, S.; Prakasha, G.V.; Harsha Kumar, S.S.S. Rhizobia and Their Bio-Partners as Novel Drivers for Functional Remediation in Contaminated Soils. Int. J. Curr. Microbiol. Appl. Sci. 2018, 7, 1673–1697. [Google Scholar] [CrossRef] [Green Version]
- Prakash, J.; Arora, N.K. Phosphate-solubilizing Bacillus sp. enhances growth, phosphorus uptake and oil yield of Menthaarvensis L. 3 Biotech 2019, 9, 126. [Google Scholar] [CrossRef] [PubMed]
- Sandilya, S.P.; Bhuyan, P.M.; Gogoi, D.K.; Kardong, D. Phosphorus Solubilization and Plant Growth Promotion Ability of Rhizobacteria of R. communis L Growing in Assam, India. Proc. Natl. Acad. Sci. India Sect. B—Biol. Sci. 2018, 88, 959–966. [Google Scholar] [CrossRef]
- Kang, Y.; Shen, M.; Wang, H.; Zhao, Q. A possible mechanism of action of plant growth-promoting rhizobacteria (PGPR) strain Bacillus pumilus WP8 via regulation of soil bacterial community structure. J. Gen. Appl. Microbiol. 2013, 59, 267–277. [Google Scholar] [CrossRef] [Green Version]
- Win, K.; Oo, A.; Ohkama-Ohtsu, N.; Yokoyama, T. Bacillus pumilus Strain TUAT-1 and Nitrogen Application in Nursery Phase Promote Growth of Rice Plants under Field Conditions. Agronomy 2018, 8, 216. [Google Scholar] [CrossRef] [Green Version]
- Aung, H.P.; Djedidi, S.; Oo, A.Z.; Aye, Y.S.; Yokoyama, T.; Suzuki, S.; Bellingrath-Kimura, S.D. Growth and 137 Cs uptake of four Brassica species influenced by inoculation with a plant growth-promoting rhizobacterium Bacillus pumilus in three contaminated farmlands in Fukushima prefecture. Jpn. Sci. Total Environ. 2015, 521, 261–269. [Google Scholar] [CrossRef] [PubMed]
- Shen, M.; Kang, Y.J.; Wang, H.L.; Zhang, X.S.; Zhao, Q.X. Effect of Plant Growth-promoting Rhizobacteria (PGPRs) on plant growth, yield, and quality of tomato (Lycopersicon esculentum Mill) under simulated seawater irrigation. J. Gen. Appl. Microbiol. 2012, 58, 253–262. [Google Scholar] [CrossRef] [PubMed] [Green Version]
- Venancio, W.S.; Gomes, J.M.; Nakatani, A.S.; Hungria, M.; Araujo, R.S. Lettuce Production under Reduced Levels of N-Fertilizer in the Presence of Plant Growth-Promoting Bacillus spp. Bacteria. J. Pure Appl. Microbiol. 2019, 13, 1941–1952. [Google Scholar] [CrossRef] [Green Version]
- Win, T.; Okazaki, K.; Ookawa, T.; Yokoyama, T.; Ohwaki, Y. Influence of rice-husk biochar and Bacillus pumilus strain TUAT-1 on yield, biomass production, and nutrient uptake in two forage rice genotypes. PLoS ONE 2019, 14, e0220236. [Google Scholar] [CrossRef] [Green Version]
- Wei, Y.; Wei, Z.; Cao, Z.; Zhao, Y.; Zhao, X.; Lu, Q.; Zhang, X. A regulating method for the distribution of phosphorus fractions based on environmental parameters related to the key phosphate-solubilizing bacteria during composting. Bioresour. Technol. 2016, 211, 610–617. [Google Scholar] [CrossRef]
- Islam, S.; Akanda, A.M.; Prova, A.; Islam, M.T.; Hossain, M.M. Isolation and Identification of Plant Growth Promoting Rhizobacteria from Cucumber Rhizosphere and Their Effect on Plant Growth Promotion and Disease Suppression. Front. Microbiol. 2016, 6, 1360. [Google Scholar] [CrossRef] [Green Version]
- Kirby, K.S.; Fox-Carter, E.; Guest, M. Isolation of deoxyribonucleic acid and ribosomal ribonucleic acid from bacteria. Biochem. J. 1967, 104, 258–262. [Google Scholar] [CrossRef] [PubMed] [Green Version]
- Pikovskaya, R.I. Mobilization of phosphorus in soil in connection with vital activity of some microbial species. Mikrobiologiya 1948, 17, 362–370. [Google Scholar]
- Kumar, V.; Narula, N. Solubilization of inorganic phosphates and growth emergence of wheat as affected by Azotobacter chroococcum mutants. Biol. Fertil. Soils 1999, 28, 301–305. [Google Scholar] [CrossRef]
- Vera, D.; Pérez, H.; Valencia, H. Aislamiento de hongos solubilizadores de fosfatos de la rizósfera del arazá (Eugenia stipitata, Myrtaceae). Acta Biol. Colomb. 2002, 7, 33–40. [Google Scholar]
- Zamora-Natera, J.F.; Bernal-Alcocer, A.; Ruiz-López, M.; Soto-Hernández, M.; Escalante-Estrada, A.; Vibrans-Lindeman, H. Perfil de alcaloides de semillas de Lupinus exaltatus Zucc. (Fabaceae) y la evaluación antifúngica del extracto alcaloideo y lupanina contra fitopatógenos. Rev. Mex. Fitopatol. 2005, 23, 124–129. [Google Scholar]
- Yu, X.; Liu, X.; Zhu, T.H.; Liu, G.H.; Mao, C. Co-inoculation with phosphate-solubilizing and nitrogen-fixing bacteria on solubilization of rock phosphate and their effect on growth promotion and nutrient uptake by walnut. Eur. J. Soil Biol. 2012, 50, 112–117. [Google Scholar] [CrossRef]
- Kalam, S.; Das, S.N.; Basu, A.; Podile, A.R. Population densities of indigenous Acidobacteria change in the presence of plant growth promoting rhizobacteria (PGPR) in rhizosphere. J. Basic Microbiol. 2017, 57, 376–385. [Google Scholar] [CrossRef]
- Zhang, H.; Murzello, C.; Sun, Y.; Kim, M.S.; Xie, X.; Jeter, R.M.; Paré, P.W. Choline and osmotic-stress tolerance induced in Arabidopsis by the soil microbe Bacillus subtilis (GB03). Mol. Plant Microbe Interact. 2010, 23, 1097–1104. [Google Scholar] [CrossRef] [PubMed] [Green Version]
- Lin, Y.; Du, D.; Si, C.; Zhao, Q.; Li, Z.; Li, P. Potential biocontrol Bacillus sp. strains isolated by an improved method from vinegar waste compost exhibit antibiosis against fungal pathogens and promote growth of cucumbers. Biol. Control 2014, 71, 7–15. [Google Scholar] [CrossRef]
- Yuan, Y.; Gao, M. Genomic analysis of a ginger pathogen Bacillus pumilus providing the understanding to the pathogenesis and the novel control strategy. Sci. Rep. 2015, 5, 10259. [Google Scholar] [CrossRef] [Green Version]
- Li, Z.; Cui, J.; Mi, Z.; Tian, D.; Wang, J.; Ma, Z.; Niu, S. Science of the Total Environment Responses of soil enzymatic activities to transgenic Bacillus thuringiensis (Bt) crops—A global meta-analysis. Sci. Total Environ. 2019, 651, 1830–1838. [Google Scholar] [CrossRef]
- Mumtaz, M.Z.; Ahmad, M.; Jamil, M.; Hussain, T. Zinc solubilizing Bacillus spp. potential candidates for biofortification in maize. Microbiol. Res. 2017, 202, 51–60. [Google Scholar] [CrossRef] [PubMed]
- Hussain, N.; Singh, A.; Saha, S.; Kumar, M.V.S.; Bhattacharyya, P.; Bhattacharya, S.S. Excellent N-fixing and P-solubilizing traits in earthworm gut-isolated bacteria: A vermicompost based assessment with vegetable market waste and rice straw feed mixtures. Bioresour. Technol. 2016, 222, 165–174. [Google Scholar] [CrossRef] [PubMed]
- Pandey, C.; Negi, Y.K.; Maheshwari, D.K.; Rawat, D.; Prabha, D. Potential of native cold tolerant plant growth promoting bacilli to enhance nutrient use efficiency and yield of Amaranthus hypochondriacus. Plant Soil 2018, 428, 307–320. [Google Scholar] [CrossRef]
- Zhu, J.; Li, M.; Whelan, M. Phosphorus activators contribute to legacy phosphorus availability in agricultural soils: A review. Sci. Total Environ. 2018, 612, 522–537. [Google Scholar] [CrossRef] [Green Version]
- Heidarzadeh, N.; Baghaee-Ravari, S. Application of Bacillus pumilus as a potential biocontrol agent of Fusarium wilt of tomato. Arch. Phytopathol. Plant Prot. 2015, 48, 841–849. [Google Scholar] [CrossRef]
- Rodríguez, L.L.; Cruz-Martín, M.; Acosta-Suárez, M.; Pichard, T.; Bermúdez-Caraballoso, I.; Alvarado-Capó, Y. Antagonismo in vitro de cepas de Bacillus spp. frente a Fusarium oxysporum f. sp. Cubense. Biotecnol. Veg. 2017, 17, 229–236. [Google Scholar]
- Olanrewaju, O.S.; Glick, B.R.; Babalola, O.O. Mechanisms of action of plant growth promoting bacteria. World J. Microbiol. Biotechnol. 2017, 33, 197. [Google Scholar] [CrossRef] [Green Version]
- Martínez, L.L.; Peniche, R.A.M.; Iturriaga, M.H.; Medrano, S.M.A.; Pacheco Aguilar, J.R. Caracterización de rizobacterias aisladas de tomate y su efecto en el crecimiento de tomate y pimiento. Rev. Fitotec. Mex. 2013, 36, 63–69. [Google Scholar]
- Mehta, P.; Walia, A.; Kulshrestha, S.; Chauhan, A.; Shirkot, C.K. Efficiency of plant growth-promoting P-solubilizing Bacillus circulans CB7 for enhancement of tomato growth under net house conditions. J. Basic Microbiol. 2015, 55, 33–44. [Google Scholar] [CrossRef] [PubMed]
- Malkoclu, M.C.; Tüzel, Y.; Oztekin, G.B.; Ozaktan, H.; Yolageldi, L. Effects of plant growth-promoting rhizobacteria on organic lettuce production. Acta Hortic. 2017, 1164, 265–271. [Google Scholar] [CrossRef]
- Díaz-Vargas, P.; Ferrera-Cerrato, R.; Almaraz-Suárez, J.J.; González, G.A. Inoculation of Plant Growth-Promoting Bacteria in Lettuce. Terra 2001, 19, 327–335. [Google Scholar]
- Miransari, M.; Smith, D.L. Plant hormones and seed germination. Environ. Exp. Bot. 2014, 99, 110–121. [Google Scholar] [CrossRef]
- Fan, X.; Zhang, S.; Mo, X.; Li, Y.; Fu, Y.; Liu, Z. Effects of Plant Growth-Promoting Rhizobacteria and N Source on Plant Growth and N and P Uptake by Tomato Grown on Calcareous Soils. Pedosphere 2017, 27, 1027–1036. [Google Scholar] [CrossRef]
- Moustaine, M.; Elkahkahi, R.; Benbouazza, A.; Benkirane, R.; Achbani, H.E. Effect of plant growth promoting rhizobacterial (PGPR) inoculation on growth in tomato (Solanum Lycopersicum L.) and characterization for direct PGP abilities in Morocco. Int. J. Environ. Agric. Biotechnol. 2017, 2, 590–596. [Google Scholar]
- Breedt, G.; Labuschagne, N.; Coutinho, T.A. Seed treatment with selected plant growth-promoting rhizobacteria increases maize yield in the field. Ann. Appl. Biol. 2017, 171, 229–236. [Google Scholar] [CrossRef]

| Fungus | Control Mycelium Diameter (cm) | Mycelium Diameter (cm) in the Presence of B. pumilus | % Inhibition |
|---|---|---|---|
| Fusarium oxysporum | 7.267 ± 0.45 a | 5 ± 0.87 b | 31.19 |
| Sclerotium cepivorum | 3 ± 0.6 a | 3.75 ± 0.35 a | −25.0 |
Publisher’s Note: MDPI stays neutral with regard to jurisdictional claims in published maps and institutional affiliations. |
© 2021 by the authors. Licensee MDPI, Basel, Switzerland. This article is an open access article distributed under the terms and conditions of the Creative Commons Attribution (CC BY) license (https://creativecommons.org/licenses/by/4.0/).
Share and Cite
Martínez-Cano, B.; García-Trejo, J.F.; Sánchez-Gutiérrez, A.E.; Toledano-Ayala, M.; Soto-Zarazúa, G.M. Isolation and Characterization of Plant Growth-Promoting Compost Bacteria That Improved Physiological Characteristics in Tomato and Lettuce Seedlings. Agriculture 2022, 12, 3. https://doi.org/10.3390/agriculture12010003
Martínez-Cano B, García-Trejo JF, Sánchez-Gutiérrez AE, Toledano-Ayala M, Soto-Zarazúa GM. Isolation and Characterization of Plant Growth-Promoting Compost Bacteria That Improved Physiological Characteristics in Tomato and Lettuce Seedlings. Agriculture. 2022; 12(1):3. https://doi.org/10.3390/agriculture12010003
Chicago/Turabian StyleMartínez-Cano, Betsie, Juan Fernando García-Trejo, Arantza Elena Sánchez-Gutiérrez, Manuel Toledano-Ayala, and Genaro M. Soto-Zarazúa. 2022. "Isolation and Characterization of Plant Growth-Promoting Compost Bacteria That Improved Physiological Characteristics in Tomato and Lettuce Seedlings" Agriculture 12, no. 1: 3. https://doi.org/10.3390/agriculture12010003
APA StyleMartínez-Cano, B., García-Trejo, J. F., Sánchez-Gutiérrez, A. E., Toledano-Ayala, M., & Soto-Zarazúa, G. M. (2022). Isolation and Characterization of Plant Growth-Promoting Compost Bacteria That Improved Physiological Characteristics in Tomato and Lettuce Seedlings. Agriculture, 12(1), 3. https://doi.org/10.3390/agriculture12010003
